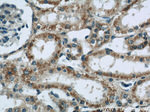
CNOT1 Antibody in Immunohistochemistry (Paraffin) (IHC (P))

Search
Proteintech
CNOT1 Polyclonal Antibody
{{$productOrderCtrl.translations['antibody.pdp.commerceCard.promotion.promotions']}}
{{$productOrderCtrl.translations['antibody.pdp.commerceCard.promotion.viewpromo']}}
{{$productOrderCtrl.translations['antibody.pdp.commerceCard.promotion.promocode']}}: {{promo.promoCode}} {{promo.promoTitle}} {{promo.promoDescription}}. {{$productOrderCtrl.translations['antibody.pdp.commerceCard.promotion.learnmore']}}
产品信息
14276-1-AP
种属反应
已发表种属
宿主/亚型
分类
类型
抗原
偶联物
形式
浓度
规格
纯化类型
保存液
内含物
保存条件
运输条件
产品详细信息
This is a rabbit polyclonal antibody raised against a region from the C-terminal CNOT1 of human origin. CNOT1 exists as many isoforms and molecular weight of isoforms are 267, 241, and 173 kDa.
Immunogen sequence: MNLDSLSLA LSQISYLVDN LTKKNYRASQ QEIQHIVNRH GPEADRHLLR CLFSHVDFSG DGKSSGKDFH QTQFLIQECA LLITKPNFIS TLSYAIDNPL HYQKSLKPAP HLFAQLSKVL KLSKVQEVIF GLALLNSSSS DLRGFAAQFI KQKLPDLLRS YIDADVSGNQ EGGFQDIAIE VLHLLLSHLL FGQKGAFGVG QEQIDAFLKT LRRDFPQERC PVVLAPLLYP EKRDILMDRI LPDSGGVAKT MMESSLADFM QEVGYGFCAS IEECRNIIVQ FGVREVTAAQ VARVLGMMAR THSGLTDGIP LQSISAPGSG IWSDGKDKSD GAQAHTWNVE VLIDVLKELN PSLNF (1-354 aa encoded by BC040523)
靶标信息
Scaffolding component of the CCR4-NOT complex which is one of the major cellular mRNA deadenylases and is linked to various cellular processes including bulk mRNA degradation, miRNA-mediated repression, translational repression during translational initiation and general transcription regulation. Additional complex functions may be a consequence of its influence on mRNA expression. Its scaffolding function implies its interaction with the catalytic complex module and diverse RNA-binding proteins mediating the complex recruitment to selected mRNA 3'UTRs. Involved in degradation of AU-rich element (ARE)-containing mRNAs probably via association with ZFP36. Mediates the recruitment of the CCR4-NOT complex to miRNA targets and to the RISC complex via association with TNRC6A, TNRC6B or TNRC6C. Acts as a transcriptional repressor. Represses the ligand-dependent transcriptional activation by nuclear receptors. Involved in the maintenance of embryonic stem (ES) cell identity. [UniProt]
仅用于科研。不用于诊断过程。未经明确授权不得转售。
生物信息学
蛋白别名: adrenal gland protein AD-005; CCR4-associated factor 1; CCR4-NOT transcription complex subunit 1; Negative regulator of transcription subunit 1 homolog; NOT1 (negative regulator of transcription 1, yeast) homolog; NOT1H; unnamed protein product
基因别名: 6030411K04Rik; AA815922; AD-005; CDC39; CNOT1; D830048B13; HPE12; KIAA1007; NOT1; NOT1H; RGD1308009; VIBOS
UniProt ID: (Human) A5YKK6, (Mouse) Q6ZQ08
Entrez Gene ID: (Human) 23019, (Rat) 291841, (Mouse) 234594